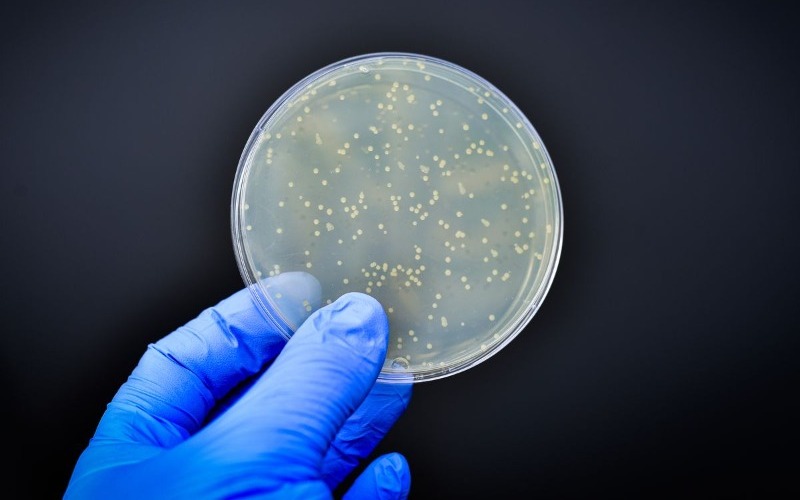

Más del 70% de los genes de resistencia a los antibióticos están en la cadena alimentaria
NOTI-AMERICA.COM | ESPAÑA
Más del 70% de los genes bacterianos conocidos de resistencia a los antibióticos están presentes en la cadena alimentaria, aunque sólo una parte de ellos es especialmente prevalente, según ha comprobado un equipo internacional de investigadores.
Un proyecto europeo, en el que han participado investigadores del Consejo Superior de Investigaciones Científicas español (CSIC), ha realizado una amplia secuenciación genómica de más de 2.000 muestras procedentes de materias primas, alimentos (como leche, carne, pescado, queso o vegetales) y superficies de entornos industriales de 100 empresas europeas, entre ellas más de 50 ubicadas en la provincia de León y en Asturias.
La investigación, cuyos resultados se han publicado en la revista Nature Microbiology, se ha centrado en el ‘resistoma’, el conjunto de genes que otorgan a las bacterias la capacidad de resistir los efectos de los antibióticos.
“Aunque se sabía que la cadena alimentaria puede actuar como vía de transmisión de bacterias resistentes a los antibióticos, hasta ahora no se había realizado un estudio tan amplio y detallado”, ha señalado el investigador del CSIC Narciso Martín Quijada, del Instituto de Biología Funcional y Genómica (IBFG) de Salamanca (España).
Entre los genes prevalentes destacan algunos que confieren resistencia a antibióticos como tetraciclinas, betalactámicos, aminoglucósidos y macrólidos, grupos clave en el tratamiento de infecciones humanas y animales, según han comprobado los investigadores.
Más del 60% de las muestras recogidas (que incluían alimentos, materias primas, superficies o herramientas) contenían al menos un gen de resistencia a antimicrobianos.
Además, los análisis han permitido identificar a las principales bacterias portadoras de estos genes y muchas de ellas son miembros del grupo ‘ESKAPEE’ (acrónimo de un grupo de seis bacterias) conocido por su papel en infecciones hospitalarias difíciles de tratar, entre ellas la Escherichia coli, Staphylococcus aureus o Klebsiella pneumoniae, ha precisado el investigador del Instituto de Productos Lácteos de Asturias (norte de España) (IPLA) Abelardo Margolles.
Un hallazgo especialmente relevante, ha destacado el investigador en una nota remitida hoy por el CSIC español, es que cerca del 40% de estos genes están asociados a elementos genéticos móviles que pueden facilitar su transferencia entre bacterias, lo que incrementa el riesgo de propagación de la resistencia.
“El estudio también aporta evidencias sobre cómo ciertos procesos industriales y condiciones de fabricación pueden influir en la presencia y transmisión de estos genes, lo que abre la puerta a mejoras en los sistemas de producción alimentaria”, ha precisado Quijada.
Los investigadores han destacado que estos hallazgos son clave para diseñar estrategias más eficaces en el uso de antibióticos y desinfectantes en la producción de alimentos y para avanzar hacia políticas de gestión que ayuden a frenar el creciente problema de la resistencia a los antimicrobianos.
Este estudio se enmarca en el proyecto europeo MASTER (Microbiome Applications for Sustainable food systems through Technologies and EnteRprise), coordinado por la Autoridad de Desarrollo Agrícola y Alimentario de Irlanda.
El estudio de secuenciación ha sido coordinado por los profesores Avelino Álvarez Ordóñez y José Francisco Cobo Díaz, de la Universidad de León (norte de España), y por el investigador Narciso Martín Quijada y en el mismo han participado el Instituto de Productos Lácteos de Asturias, el Instituto de Agroquímica y Tecnología de Alimentos (IATA-CSIC), además de varias universidades y centros de investigación de Italia, Austria, Irlanda e Islandia.



